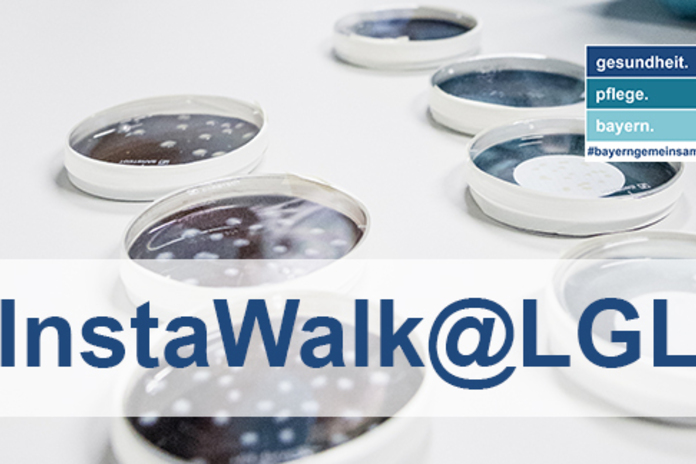

Dieses Event liegt in der Vergangenheit. Hier geht’s zu den aktuellen Events.
Führung
New Work & Health
Anfänger:innen
2022
Event beendet
InstaWalk@LGL
08.07.2022
|
17:00
-
22:00
Uhr
Bayerisches Landesamt für Gesundheit und Lebensmittelsicherheit (LGL)
|
Eggenreuther Weg 43
43,
91058
Erlangen
Loading...
PCR-Tests, Veterinärmedizin, Spielzeuglabor...
Wir laden eine kleine Gruppe von Instagramern ein auf eine spannende Fotoreise durch eine der wohl interessantesten Behörden Bayerns.
Veranstaltet von
Bayerisches Staatsministerium für Gesundheit und Pflege
Christian Wolff
chwolff@me.comInstaWalk@LGL
08.07.2022
|
17:00
-
22:00
Uhr
Bayerisches Landesamt für Gesundheit und Lebensmittelsicherheit (LGL)
|
Eggenreuther Weg 43
43,
91058
Erlangen
Event beendet
